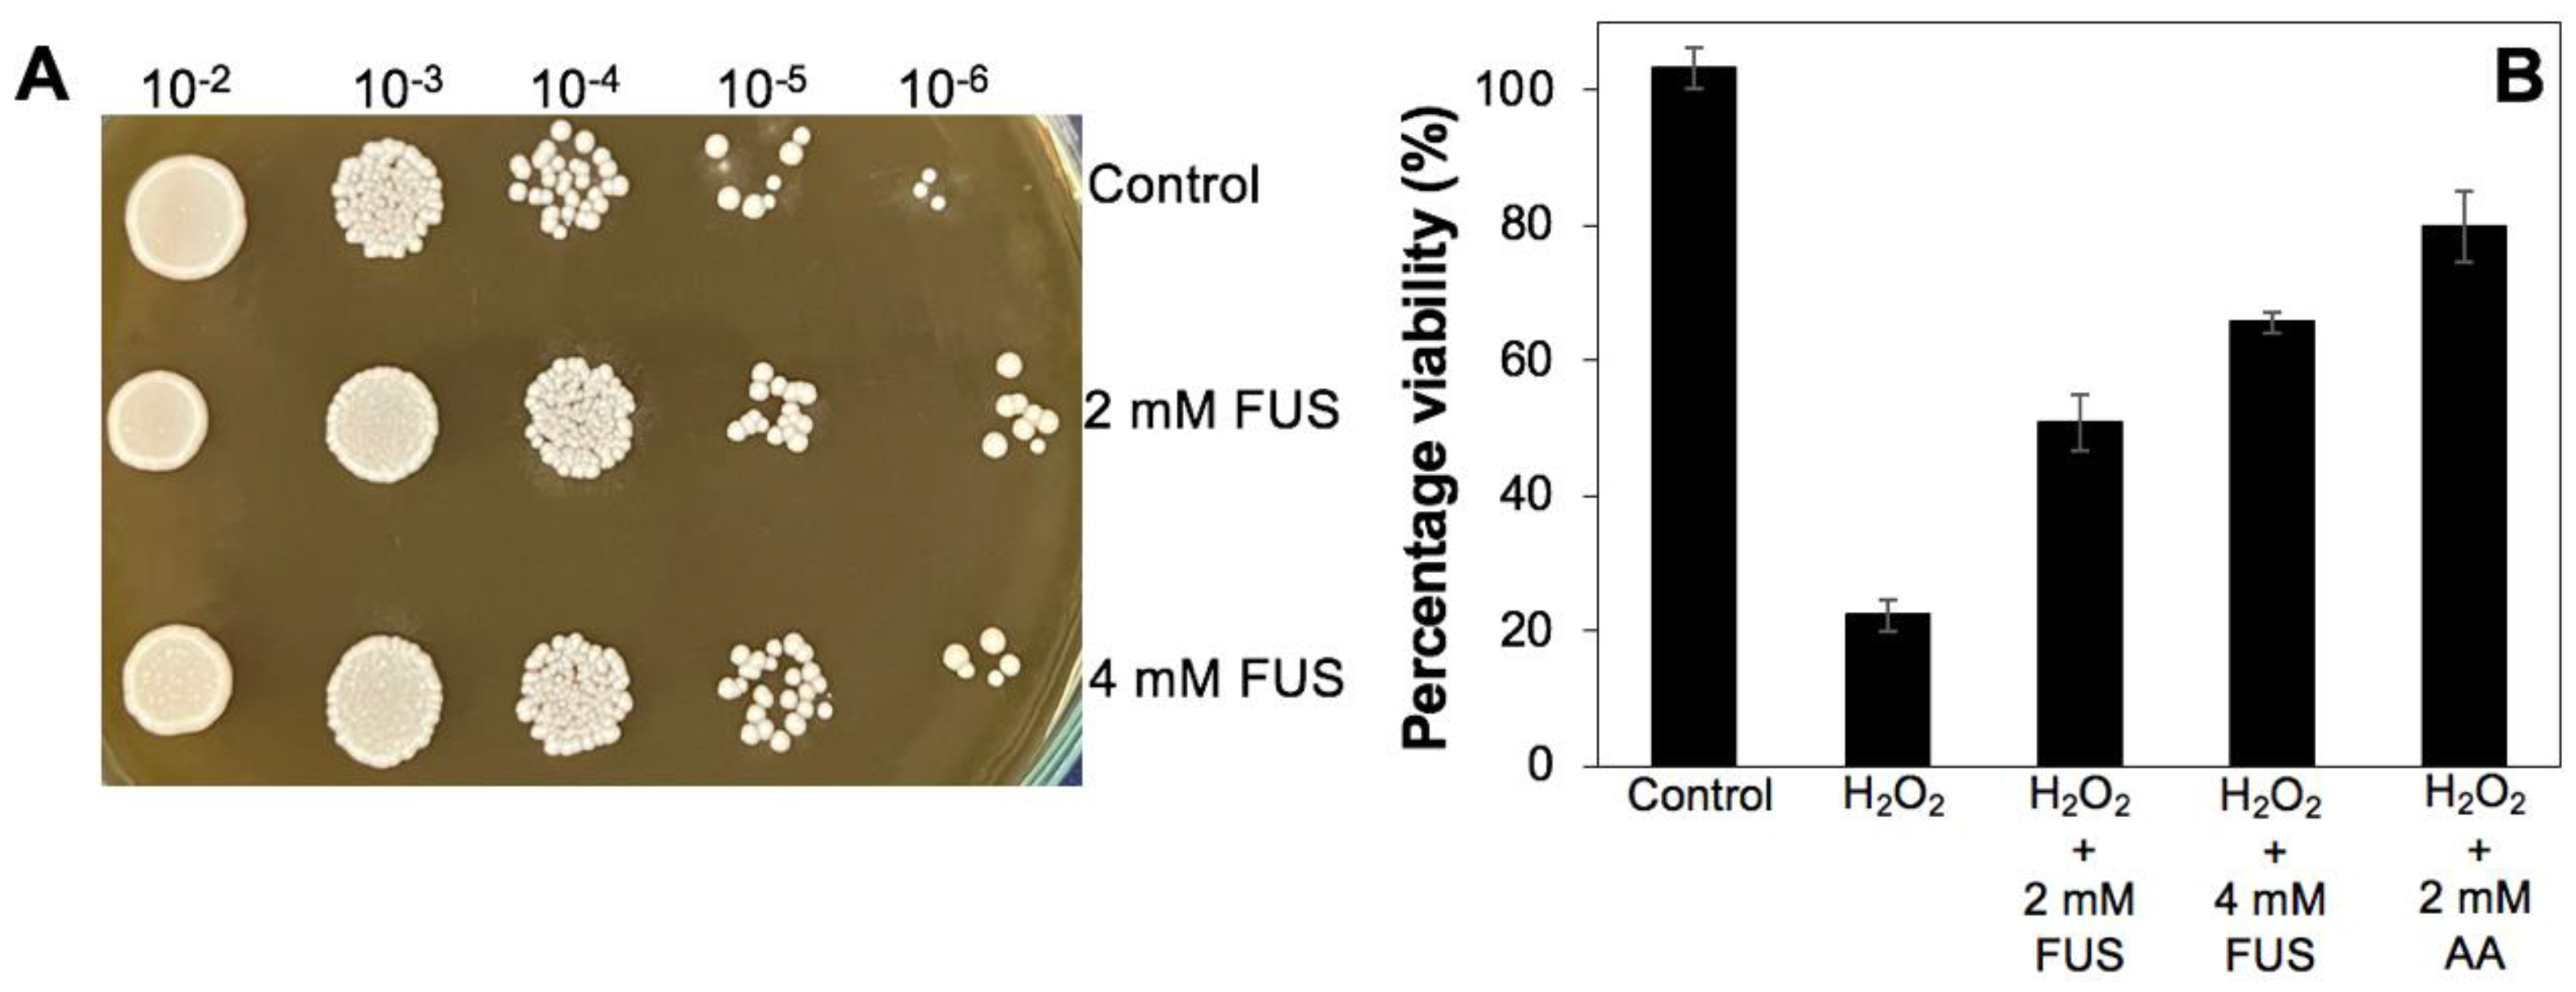
Applsci 14 02048 g003

Fusarium foetens AQF6 Isolated from Amentotaxus ynnanensis H.L.Li as a Prolific Source of Antioxidant Compounds
Abstract
1. Introduction
2. Materials and Methods
2.1. Sample Collection and Endophytic Fungi Isolation
2.2. Identification of Endophytic Fungi
2.3. Evaluation of Total Polyphenol and Flavonoid Contents Present in the Fungal Extracts
2.4. Antioxidant Activity
2.5. Large-Scale Fermentation, Extraction, and Identification of Pure Compounds
2.6. Evaluation of Protective Effects of FUS on Yeast Cells during Oxidative Stress Provoked by H2O2
2.7. Statistical Analysis
3. Results
3.1. Isolation and Identification of Endophytic Fungi
3.2. Preliminary Phytochemical Screening of Fungal Crude Extracts
3.3. Evaluation of Antioxidant Activity
3.4. Structural Elucidation of Major Compounds
3.5. Antioxidant Potential of Pure Compounds
3.6. Protective Effect of FUS on Yeast Cells during Oxidative Stress
4. Discussion
5. Conclusions
Supplementary Materials
Author Contributions
Funding
Institutional Review Board Statement
Informed Consent Statement
Data Availability Statement
Acknowledgments
Conflicts of Interest
References
- Chandra, S. Endophytic fungi: Novel sources of anticancer lead molecules. Appl. Microbiol. Biotechnol. 2012, 95, 47–59. [Google Scholar] [CrossRef]
 - Vu, T.H.N.; Quach, N.T.; Pham, Q.A.; Le, P.C.; Nguyen, V.T.; Le, T.T.X.; Do, T.T.; Anh, D.H.; Quang, T.H.; Chu, H.H.; et al. Fusarium solani PQF9 isolated from Podocarpus pilgeri growing in Vietnam as a new producer of paclitaxel. Indian J. Microbiol. 2023, 63, 596–603. [Google Scholar] [CrossRef] [PubMed]
 - Gupta, A.; Meshram, V.; Gupta, M.; Goyal, S.; Qureshi, K.A.; Jaremko, M.; Shukla, K.K. Fungal endophytes: Microfactories of novel bioactive compounds with therapeutic interventions; A comprehensive review on the biotechnological developments in the field of fungal endophytic biology over the last decade. Biomolecules 2023, 13, 1038. [Google Scholar] [CrossRef]
 - Khan, N.; Afroz, F.; Begum, M.N.; Roy Rony, S.; Sharmin, S.; Moni, F.; Mahmood Hasan, C.; Shaha, K.; Sohrab, M.H. Endophytic Fusarium solani: A rich source of cytotoxic and antimicrobial napthaquinone and aza-anthraquinone derivatives. Toxicol. Rep. 2018, 5, 970–976. [Google Scholar] [CrossRef]
 - Tung, Q.N.; Loi, V.V.; Busche, T.; Nerlich, A.; Mieth, M.; Milse, J.; Kalinowski, J.; Hocke, A.C.; Antelmann, H. Stable integration of the Mrx1-roGFP2 biosensor to monitor dynamic changes of the mycothiol redox potential in Corynebacterium glutamicum. Redox Biol. 2019, 20, 514–525. [Google Scholar] [CrossRef] [PubMed]
 - Zahoor, H.; Watchaputi, K.; Hata, J.; Pabuprapap, W.; Suksamrarn, A.; Chua, L.S.; Soontorngun, N. Model yeast as a versatile tool to examine the antioxidant and anti-ageing potential of flavonoids, extracted from medicinal plants. Front. Pharmacol. 2022, 13, 980066. [Google Scholar] [CrossRef] [PubMed]
 - Rai, N.; Keshri, P.K.; Gupta, P.; Verma, A.; Kamble, S.C.; Singh, S.K.; Gautam, V. Bioprospecting of fungal endophytes from Oroxylum indicum (L.) Kurz with antioxidant and cytotoxic activity. PLoS ONE 2022, 17, e0264673. [Google Scholar] [CrossRef] [PubMed]
 - Vu, T.H.N.; Pham, N.S.; Le, P.C.; Pham, Q.A.; Quach, N.T.; Nguyen, V.T.; Do, T.T.; Chu, H.H.; Phi, Q.T. Distribution, cytotoxicity, and antioxidant activity of fungal endophytes isolated from Tsuga chinensis (Franch.) Pritz. in Ha Giang province, Vietnam. Ann. Microbiol. 2022, 72, 36. [Google Scholar] [CrossRef]
 - Zhang, J.; Cao, Z.P.; Li, S.; Liu, M.M.; Huo, X.W. The complete chloroplast genome sequence of Amentotaxus yunnanensis (Taxaceae). Mitochondrial DNA B Resour. 2019, 4, 2477–2478. [Google Scholar] [CrossRef] [PubMed]
 - Li, S.H.; Zhang, H.J.; Niu, X.M.; Yao, P.; Sun, H.D.; Fong, H.H. Chemical constituents from Amentotaxus yunnanensis and Torreya yunnanensis. J. Nat. Prod. 2003, 66, 1002–1005. [Google Scholar] [CrossRef]
 - Quach, N.T.; Ngo, C.C.; Nguyen, T.H.; Nguyen, P.L.; Vu, T.H.N.; Phan, T.H.T.; Nguyen, Q.H.; Le, T.T.M.; Chu, H.H.; Phi, Q.T. Genome-wide comparison deciphers lifestyle adaptation and glass biodeterioration property of Curvularia eragrostidis C52. Sci. Rep. 2022, 12, 11411. [Google Scholar] [CrossRef]
 - da Silva, M.H.R.; Cueva-Yesquén, L.G.; Júnior, S.B.; Garcia, V.L.; Sartoratto, A.; de Angelis, D.d.F.; de Angelis, D.A. Endophytic fungi from Passiflora incarnata: An antioxidant compound source. Arch. Microbiol. 2020, 202, 2779–2789. [Google Scholar] [CrossRef] [PubMed]
 - Tang, Z.; Qin, Y.; Chen, W.; Zhao, Z.; Lin, W.; Xiao, Y.; Chen, H.; Liu, Y.; Chen, H.; Bu, T.; et al. Diversity, chemical constituents, and biological activities of endophytic fungi isolated from Ligusticum chuanxiong Hort. Front. Microbiol. 2021, 12, 771000. [Google Scholar] [CrossRef]
 - Oliveira, D.; Dias, M.I.; Barros, L.; Custódio, L.; Oliveira, R. Antigenotoxic properties of the halophyte Polygonum maritimum L. highlight its potential to mitigate oxidative stress-related damage. Sci. Rep. 2023, 13, 3727. [Google Scholar] [CrossRef] [PubMed]
 - Evidente, A.; Andolfi, A.; Maddau, L.; Franceschini, A.; Marras, F. Biscopyran, a phytotoxic hexasubstituted pyranopyran produced by Biscogniauxia mediterranea, a fungus pathogen of Cork Oak. J. Nat. Prod. 2005, 68, 568–571. [Google Scholar] [CrossRef]
 - Kwon, Y.S.; Kim, C.M. Antioxidant constituents from the stem of Sorghum bicolor. Arch. Pharm. Res. 2003, 26, 535. [Google Scholar] [CrossRef]
 - Agerbirk, N.; Warwick, S.I.; Hansen, P.R.; Olsen, C.E. Sinapis phylogeny and evolution of glucosinolates and specific nitrile degrading enzymes. Phytochemistry 2008, 69, 2937–2949. [Google Scholar] [CrossRef] [PubMed]
 - Kwak, J.H.; Kang, M.W.; Roh, J.H.; Choi, S.U.; Zee, O.P. Cytotoxic phenolic compounds from Chionanthus retusus. Arch. Pharm. Res. 2009, 32, 1681–1687. [Google Scholar] [CrossRef]
 - Carvalho, M.J.; Carvalho, L.M.; Ferreira, A.M.; Silva, A.M.S. A new xanthone from Hedychium gardnerianum. Nat. Prod. Res. 2003, 17, 445–449. [Google Scholar] [CrossRef]
 - Gutierrez-Lugo, M.-T.; Woldemichael, G.M.; Singh, M.P.; Suarez, P.A.; Maiese, W.M.; Montenegro, G.; Timmermann, B.N. Isolation of three new naturally occurring compounds from the culture of Micromonospora sp. P1068. Nat. Prod. Res. 2005, 19, 645–652. [Google Scholar] [CrossRef]
 - Singh, S.P.; Parmar, S.S.; Stenberg, V.I.; Farnum, S.A. Carbon-13 nuclear magnetic resonance spectra of anti-inflammatory drugs: Phenylbutazone, oxyphenbutazone and indomethacin. J. Heterocycl. Chem. 1978, 15, 13–16. [Google Scholar] [CrossRef]
 - Kendall, J.K.; Fisher, T.H.; Schultz, H.P.; Schultz, T.P. An improved synthesis of 6,8-dimethoxy-3-methylisocoumarin, a fungal metabolite precursor. J. Org. Chem. 1989, 54, 4218–4220. [Google Scholar] [CrossRef]
 - Malak, L.G.; Bishay, D.W.; Abdel-Baky, A.M.; Moharram, A.M.; Cutler, S.J.; Ross, S.A. New anthraquinone derivatives from Geosmithia lavendula. Nat. Prod. Commun. 2013, 8, 1934578X1300800215. [Google Scholar] [CrossRef]
 - Venkateswarlu, S.; Panchagnula, G.K.; Guraiah, M.B.; Subbaraju, G.V. Isoaurostatin: Total synthesis and structural revision. Tetrahedron 2005, 61, 3013–3017. [Google Scholar] [CrossRef]
 - Wenkert, E.; Gottlieb, H.E. Carbon-13 nuclear magnetic resonance spectroscopy of flavonoid and isoflavonoid compounds. Phytochemistry 1977, 16, 1811–1816. [Google Scholar] [CrossRef]
 - Ciuffreda, P.; Casati, S.; Manzocchi, A. Spectral assignments and reference data complete 1H and 13C NMR spectral assignment of α- and β-adenosine, 2’-deoxyadenosine and their acetate derivatives. Magn. Reson. Chem. 2007, 45, 781–784. [Google Scholar] [CrossRef] [PubMed]
 - Mehnaz, S.; Saleem, R.S.Z.; Yameen, B.; Pianet, I.; Schnakenburg, G.; Pietraszkiewicz, H.; Valeriote, F.; Josten, M.; Sahl, H.-G.; Franzblau, S.G.; et al. Lahorenoic Acids A–C, ortho-dialkyl-substituted aromatic acids from the biocontrol strain Pseudomonas aurantiaca PB-St2. J. Nat. Prod. 2013, 76, 135–141. [Google Scholar] [CrossRef]
 - Evidente, A.; Ricciardiello, G.; Andolfi, A.; Sabatini, M.A.; Ganassi, S.; Altomare, C.; Favilla, M.; Melck, D. Citrantifidiene and citrantifidiol: Bioactive metabolites produced by Trichoderma citrinoviride with potential antifeedant activity toward Aphids. J. Agric. Food. Chem. 2008, 56, 3569–3573. [Google Scholar] [CrossRef] [PubMed]
 - Cheng, X.; Wei, Z.; Pu, S.; Xiang, M.; Yan, A.; Zhang, Y.; Wang, X. Diversity of endophytic fungi of Paeonia lactiflora Pallas and screening for fungal paeoniflorin producers. FEMS Microbiol. Lett. 2018, 365, fny263. [Google Scholar] [CrossRef]
 - Santos, T.F.B.; Dos Santos Carvalho, C.; de Almeida, M.A.; Delforno, T.P.; Duarte, I.C.S. Endophytic fungi isolated from Brazilian medicinal plants as potential producers of antioxidants and their relations with anti-inflammatory activity. 3 Biotech 2020, 10, 223. [Google Scholar] [CrossRef] [PubMed]
 - Khan, M.; Tanaka, K. Purpureocillium lilacinum for plant growth promotion and biocontrol against root-knot nematodes infecting eggplant. PLoS ONE 2023, 18, e0283550. [Google Scholar] [CrossRef] [PubMed]
 - Li, W.; Luo, T.; Li, J.; Zhang, J.; Wu, M.; Yang, L.; Li, G. Antifungal activity and biocontrol potential of Simplicillium lamellicola JC-1 against multiple fungal pathogens of oilseed rape. J. Fungi 2022, 9, 57. [Google Scholar] [CrossRef] [PubMed]
 - Lamprecht, S.C.; Tewoldemedhin, Y.T. Fusarium species associated with damping-off of rooibos seedlings and the potential of compost as soil amendment for disease suppression. S. Afr. J. Bot. 2017, 110, 110–117. [Google Scholar] [CrossRef]
 - González-Jartín, J.M.; Alfonso, A.; Sainz, M.J.; Vieytes, M.R.; Aguín, O.; Ferreiroa, V.; Botana, L.M. First report of Fusarium foetens as a mycotoxin producer. Mycotoxin Res. 2019, 35, 177–186. [Google Scholar] [CrossRef] [PubMed]
 - Xu, M.; Huang, Z.; Zhu, W.; Liu, Y.; Bai, X.; Zhang, H. Fusarium-derived secondary metabolites with antimicrobial effects. Molecules 2023, 28, 3424. [Google Scholar] [CrossRef]
 - Zheng, K.-X.; Jiang, Y.; Jiang, J.-X.; Huang, R.; He, J.; Wu, S.-H. A new phthalazinone derivative and a new isoflavonoid glycoside from lichen-associated Amycolatopsis sp. Fitoterapia 2019, 135, 85–89. [Google Scholar] [CrossRef]
 - Chaturvedi, S.; Tiwari, V.; Gangadhar, N.M.; Rashid, M.; Sultana, N.; Singh, S.K.; Shukla, S.; Wahajuddin, M. Isoformononetin, a dietary isoflavone protects against streptozotocin induced rat model of neuroinflammation through inhibition of NLRP3/ASC/IL-1 axis activation. Life Sci. 2021, 286, 119989. [Google Scholar] [CrossRef]
 - Singh, S. Salicylic acid elicitation improves antioxidant activity of spinach leaves by increasing phenolic content and enzyme levels. Food Chem. Ad. 2023, 2, 100156. [Google Scholar] [CrossRef]
 - Kinjo, Y.; Wada, K.; Oe, M.; Hou, D.-X.; Takahashi, M. Effects of p-hydroxybenzaldehyde and p-hydroxyacetophenone from non-centrifuged Cane Sugar, Kokuto, on serum corticosterone, and liver conditions in chronically stressed mice fed with a high-fat diet. Food Sci. Technol. Res. 2020, 26, 501–507. [Google Scholar] [CrossRef]

| Endophytic Fungi | Plant Organ | Polyphenols  (mg QAE/g)  | Flavonoids  (mg QE/g)  | The Free-Radical Scavenging Activity (%) | |
|---|---|---|---|---|---|
| DPPH | Hydroxyl | ||||
| AQF1 | Stem | 71.36 ± 0.55 c | 47.92 ± 0.9 a | 45.43 ± 2.88 a | 62.45 ± 2.20 c | 
| AQF2 | Leaf | 84.27 ± 0.34 d | 65.21 b ± 1.67 b | 61.43 ± 2.68 c | 37.18 ± 2.22 a | 
| AQF3 | Root | - | - | - | - | 
| AQF4 | Root | 87.53 ± 0.23 d | 81.25 ± 1.88 d | 58.55 ± 1.93 c | 43.59 ± 2.67 b | 
| AQF5 | Root | - | - | - | - | 
| AQF6 | Root | 117.76 ± 0.94 h | 169.01 ± 2.09 f | 95.75 ± 1.06 f | 85.66 ± 1.91 e | 
| AQF7 | Root | - | - | - | - | 
| AQF8 | Root | 101.84 ± 5.5 f | 101.44 ± 2.70 e | 84.85 ± 2.2 e | 72.41 ± 1.43 d | 
| AQF9 | Root | - | - | - | - | 
| AQF13 | Stem | 106.67 ± 1.28 g | 73.46 ± 1.89 c | 93.51 ± 1.31 f | 45.18 ± 1.52 b | 
| AQF15 | Stem | - | - | - | - | 
| AQF16 | Stem | - | - | - | - | 
| AQF18 | Stem | 57.68 ± 1.16 a | 47.19 ± 0.36 a | 76.66 ± 1.33 d | 63.07 c ± 1.60 c | 
| AQF19 | Stem | 67.06 ± 0.54 b | 70.63 ± 1.56 c | 54.08 ± 1.50 b | 84.86 ± 2.15 e | 
| AQF21 | Leaf | - | - | - | - | 
| AQF23 | Leaf | 94.82 ± 0.78 e | 64.84 ± 1.46 b | 93.72 ± 3.12 f | 74.09 ± 2.22 d | 
| Ascorbic acid | 96.32 ± 3.97 f | 99.19 ± 0.23 f | |||
| Compounds | The Free-Radical Scavenging Activity IC50 (mM) | |
|---|---|---|
| DPPH | Hydroxyl | |
| FUS (1) | 1.76 ± 0.32 c | 0.95 ± 0.37 a,b | 
| Phenylacetic acid (2) | 3.73 ± 0.39 d | 4.46 ± 0.86 d | 
| p-hydroxybenzaldehyde (3) | 1.65 ± 0.27 c | 0.36 ± 0.09 a | 
| p-hydroxybenzeneacetic acid (4) | nd | nd | 
| 2-(4-hydroxyphenyl)ethanol (5) | 5.33 e ± 0.06 | 3.97 d ± 0.11 | 
| Salicylic acid (6) | 0.95 ± 0.08 b | 1.92 ± 0.61 c | 
| 2-hydroxybenzeneacetic acid (7) | nd | nd | 
| Indole-3-acetic acid (8) | nd | nd | 
| 6,8-dihydroxy-3-methylisocoumarin (9) | nd | nd | 
| 2-acetyl-1,4,5,7-tetrahydroxy-9,10-anthraquinone (10) | nd | nd | 
| Daidzein (11) | nd | nd | 
| Isoformononetin (12) | 1.02 ± 0.09 c | 1.14 ± 0.25 b | 
| β-adesonine (13) | nd | nd | 
| β-2′-deoxyadenosine (14) | nd | nd | 
| Cyclo-Pro-Val (15) | nd | nd | 
| Ascorbic acid | 0.42 ± 0.18 a | 0.82 ± 0.17 a,b | 
Disclaimer/Publisher’s Note: The statements, opinions and data contained in all publications are solely those of the individual author(s) and contributor(s) and not of MDPI and/or the editor(s). MDPI and/or the editor(s) disclaim responsibility for any injury to people or property resulting from any ideas, methods, instructions or products referred to in the content.  | 
© 2024 by the authors. Licensee MDPI, Basel, Switzerland. This article is an open access article distributed under the terms and conditions of the Creative Commons Attribution (CC BY) license (https://creativecommons.org/licenses/by/4.0/).
Share and Cite
Vu, T.H.N.; Pham, N.S.; Quach, N.T.; Le, P.C.; Pham, Q.A.; Ngo, C.C.; Nguyen, V.T.; Anh, D.H.; Quang, T.H.; Chu, H.H.; et al. Fusarium foetens AQF6 Isolated from Amentotaxus ynnanensis H.L.Li as a Prolific Source of Antioxidant Compounds. Appl. Sci. 2024, 14, 2048. https://doi.org/10.3390/app14052048
Vu THN, Pham NS, Quach NT, Le PC, Pham QA, Ngo CC, Nguyen VT, Anh DH, Quang TH, Chu HH, et al. Fusarium foetens AQF6 Isolated from Amentotaxus ynnanensis H.L.Li as a Prolific Source of Antioxidant Compounds. Applied Sciences. 2024; 14(5):2048. https://doi.org/10.3390/app14052048
Chicago/Turabian StyleVu, Thi Hanh Nguyen, Ngoc Son Pham, Ngoc Tung Quach, Phuong Chi Le, Quynh Anh Pham, Cao Cuong Ngo, Van The Nguyen, Do Hoang Anh, Tran Hong Quang, Hoang Ha Chu, and et al. 2024. "Fusarium foetens AQF6 Isolated from Amentotaxus ynnanensis H.L.Li as a Prolific Source of Antioxidant Compounds" Applied Sciences 14, no. 5: 2048. https://doi.org/10.3390/app14052048
APA StyleVu, T. H. N., Pham, N. S., Quach, N. T., Le, P. C., Pham, Q. A., Ngo, C. C., Nguyen, V. T., Anh, D. H., Quang, T. H., Chu, H. H., & Phi, Q.-T. (2024). Fusarium foetens AQF6 Isolated from Amentotaxus ynnanensis H.L.Li as a Prolific Source of Antioxidant Compounds. Applied Sciences, 14(5), 2048. https://doi.org/10.3390/app14052048
        
